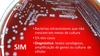
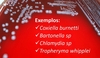
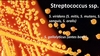

O que é endocardite?

O que é endocardite?

Qual a mortalidade na endocardite?

Qual o principal fator de risco de endocardite no Brasil?
Qual o agente mais comum?

Quais os principais fatores associados da endocardite nos países desenvolvidos?

Como é o quadro clínico de endocardite por S. aureaus?

Como as endocardites pode ser classificadas?

Como as bacterias crescem na valva?

Como é o quadro clínico da endocardite?

Quais as formas de apresentação possíveis na endocardite?

Qual o quadro clínico de forma geral da endocardite?

O que pensar diante de um caso de febre e fenômenos embólicos?

Quando pensar em endocardite infecciosa?

Quando pensar em endocardite infecciosa?

Qual a principal alteração no exame físico da endocardite

Quais alteações neurológicas e periféricas podem ocorrer na endocardite?

Quais são os fenômenos vasculares na endocardite?
- Manchar de Janeway
- Petequias conjuntivais ocular ou palpebras
O q são as lesões de Janeway?
São indolores

Qual a diferença das embolizações periféricas na endocardite por enterococco?

Qual a diferença das embolizações periféricas na endocardite por enterococco?

Quais são os fenômenos imunologicos?
- Manchas de Roth
- Nódulos de Osler
O que são as manchas de Roth?

O que são os nódulos de Osler?
Dolorosos

Quais alterações laboratoriais podem estar presentes na endocardite?